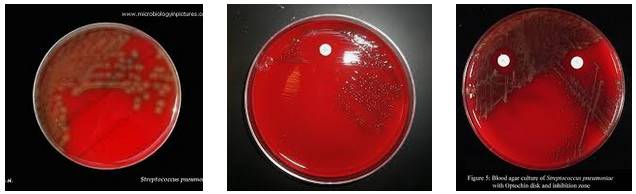
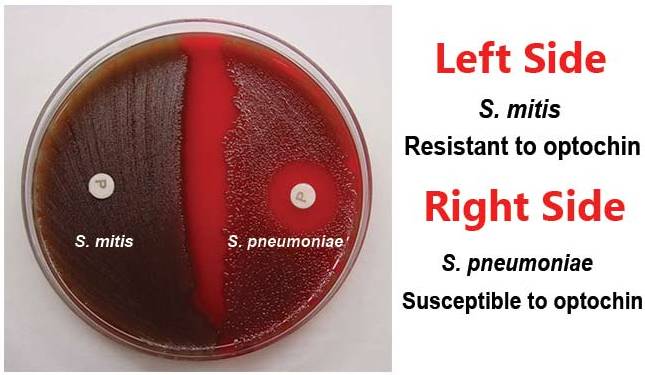

Cùng với sự phát triển kháng thuốc của nhiều tác nhân vi khuẩn, virus, nấm và ký sinh trùng hiện nay đang diễn ra trên phạm vi toàn cầu và ngay tại Việt Nam. Trong đó, đáng chú ý đến các chủng phế cầu Strptococcus pneumoniae với nhiều loại kháng sinh khác nhau, ngay cả thuốc kháng sinh phổ rộng có thể do nhiều nuyên do khác nhau từ việc sử dụng thuốc không đúng mục đích, sử dụng thuốc tràn lan và quá rộng rãi tại các cơ sở điều trị và kê đơn thuốc không hợp lý cũng như sử dụng thuốc tại cộng đồng trong nhiều năm qua. 
Trước tình trạng đó, việc nghiên cứu đánh giá dịch tễ học kháng thuốc, nghiên cứu thuốc mới hoặc phối hợp thuốc chống kháng và chế tạo vaccine để phòng bệnh cho phế cầu hiện đang là hướng đi của nhiều quốc gia trên thế giới cũng như tại Việt Nam. Nhân đây, chúng tôi xin chia sẻ thông tin một số nghiên cứu liên quan đến các vấn đề sức khỏe nói trên như cập nhật thông tin thế giới và cho thấy trong nghiên cứu vẫn còn nhiều điều thú vị và còn nhiều khoảng trống để chúng ta cần phải nghiên cứu và lấp lỗ hỗng này.
Antibiotic resistance in Streptococcus pneumoniae isolated from children.
Nasrin D, Collignon PJ, Wilson EJ, Pilotto LS, Douglas RM.J Paediatr Child Health. 1999 Dec;35(6):558-61.PMID: 10634983 Similar articles Select item 1273720293.
Streptococcus pneumoniae nasopharyngeal colonization in young healthy children: rate of carriage, serotype distribution, and antibiotic resistance.
Mosca A, Carucci A, Santacroce L, Schettini F, De Mattia D, Miragliotta G.New Microbiol. 2003 Apr;26(2):187-92.PMID: 12737202 Similar articles Select item 1936636294.
Management of antibiotic-resistant Streptococcus pneumoniae infections and the use of pneumococcal conjugate vaccines.
Picazo JJ.Clin Microbiol Infect. 2009 Apr;15 Suppl 3:4-6. doi: 10.1111/j.1469-0691.2009.02723.x. Review. PMID: 19366362 Free Article Similar articles Select item 980262895.
Dynamics of pneumococcal nasopharyngeal colonization during the first days of antibiotic treatment in pediatric patients.
Dagan R, Leibovitz E, Greenberg D, Yagupsky P, Fliss DM, Leiberman A.Pediatr Infect Dis J. 1998 Oct;17(10):880-5.PMID: 9802628 Similar articlesSelect item 2184870896.
Hình 1
Increasing antibiotic resistance in Streptococcus pneumoniae colonizing children attending day-care centres in Singapore.
Vasoo S, Singh K, Hsu LY, Chiew YF, Chow C, Lin RT, Tambyah PA.Respirology. 2011 Nov;16(8):1241-8. doi: 10.1111/j.1440-1843.2011.02036.x.PMID: 21848708 Similar articlesSelect item 1573050797.
High nasopharyngeal carriage of drug resistant Streptococcus pneumoniae and Haemophilus influenzae in North Indian schoolchildren.
Jain A, Kumar P, Awasthi S.Trop Med Int Health. 2005 Mar;10(3):234-9.PMID: 15730507 Free Article Similar articles Select item 1033271898.
Carriage of respiratory tract pathogens and molecular epidemiology of Streptococcus pneumoniae colonization in healthy children attending day care centers in Lisbon, Portugal.
De Lencastre H, Kristinsson KG, Brito-Avô A, Sanches IS, Sá-Leão R, Saldanha J, Sigvaldadottir E, Karlsson S, Oliveira D, Mato R, Aires de Sousa M, Tomasz A.Microb Drug Resist. 1999 Spring;5(1):19-29.PMID: 10332718 Similar articlesSelect item 167079999.
Antimicrobial resistance of pneumococci in children with acute lower respiratory tract infection in Pakistan.
Mastro TD, Ghafoor A, Nomani NK, Ishaq Z, Anwar F, Granoff DM, Spika JS, Thornsberry C, Facklam RR.Lancet. 1991 Jan 19;337(8734):156-9.PMID: 1670799 Similar articlesSelect item 28870173100.
Children with respiratory tract infections in Swedish primary care; prevalence of antibiotic resistance in common respiratory tract pathogens and relation to antibiotic consumption.
Tyrstrup M, Melander E, Hedin K, Beckman A, Mölstad S.BMC Infect Dis. 2017 Sep 4;17(1):603. doi: 10.1186/s12879-017-2703-3.PMID: 28870173 Free PMC Article Similar articles 
Carriage of penicillin-susceptible and non-susceptible pneumococci in healthy young children in Göteborg, Sweden.
Borres MP, Alestig K, Krantz I, Larsson P, Norvenius G, Stenqvist K.J Infect. 2000 Mar;40(2):141-4.PMID: 10841089 Similar articles Select item 28414696102.
Decrease in Pneumococcal Otitis Media Cultures With Concomitant Increased Antibiotic Susceptibility in the Pneumococcal Conjugate Vaccines Era.
Jabarin B, Pitaro J, Lazarovitch T, Gavriel H, Muallem-Kalmovich L, Eviatar E, Marom T.Otol Neurotol. 2017 Jul;38(6):853-859. doi: 10.1097/MAO.0000000000001419.PMID: 28414696 Similar articles Select item 23562996103.
Impact of the revised penicillin susceptibility breakpoints for Streptococcus pneumoniae on antimicrobial resistance rates of meningeal and non-meningeal pneumococcal strains.
Al-Waili BR, Al-Thawadi S, Hajjar SA.Ann Saudi Med. 2013 Mar-Apr;33(2):111-5. doi: 10.5144/0256-4947.2013.111.PMID: 23562996 Free PMC Article Similar articles Select item 29405160104.
Hình 2
Demographic profile of healthy children with nasopharyngeal colonisation of Streptococcus pneumoniae: A research paper.
Raman R, Sankar J, Putlibai S, Raghavan V.Indian J Med Microbiol. 2017 Oct-Dec;35(4):607-609. doi: 10.4103/ijmm.IJMM_15_347.PMID: 29405160 Free Article Similar articles Select item 24604030105.
Low prevalence of pneumococcal carriage and high serotype and genotype diversity among adults over 60 years of age living in Portugal.
Almeida ST, Nunes S, Santos Paulo AC, Valadares I, Martins S, Breia F, Brito-Avô A, Morais A, de Lencastre H, Sá-Leão R.PLoS one. 2014 Mar 6;9(3):e90974. doi: 10.1371/journal.pone.0090974. eCollection 2014.PMID: 24604030 Free PMC Article Similar articles Select item 27798547106.
Streptococcus pneumoniae Serotypes and Antibiotic Susceptibility Patterns in Middle Ear Fluid Isolates During Acute Otitis Media and Nasopharyngeal Isolates During Community-acquired Alveolar Pneumonia in Central Romania.
Lixandru RI, Falup-Pecurariu C, Bleotu L, Mercas A, Leibovitz E, Dagan R, Greenberg D, Falup-Pecurariu O.Pediatr Infect Dis J. 2017 Feb;36(2):151-154. doi: 10.1097/INF.0000000000001379.PMID: 27798547 Similar articles Select item 20300795107.
The trend of drug-resistant Streptococcus pneumoniae from nasopharynx of children.
Matsumoto A, Takeyama A, Hashimoto K, Ito M, Katayose M, Kato K, Kawasaki Y, Hosoya M.J Infect Chemother. 2010 Aug;16(4):255-9. doi: 10.1007/s10156-010-0048-6. Epub 2010 Mar 19.PMID: 20300795 Similar articlesSelect item 26368823108.
Epidemiology of invasive pneumococcal disease in Saudi Arabian children younger than 5years of age.
Almazrou Y, Shibl AM, Alkhlaif R, Pirçon JY, Anis S, Kandeil W, Hausdorff WP.J Epidemiol Glob Health. 2016 Jun;6(2):95-104. doi: 10.1016/j.jegh.2015.08.002. Epub 2015 Sep 11.PMID: 26368823 Free Article Similar articles Select item 3172328109.
Antibiotic susceptibility and serotype distribution of Streptococcus pneumoniae in Malaysian children.
Cheong YM, Jegathesan M, Henrichsen J, Wong YH, Ng AJ, Louis A.J Trop Pediatr. 1988 Aug;34(4):182-5. doi: 10.1093/tropej/34.4.182. No abstract available. PMID: 3172328 Similar articles Select item 27956163110.
Invasive pneumococcal disease in children aged younger than 5 years in India: a surveillance study.
Manoharan A, Manchanda V, Balasubramanian S, Lalwani S, Modak M, Bai S, Vijayan A, Shet A, Nagaraj S, Karande S, Nataraj G, Yewale VN, Joshi SA, Iyer RN, Santosham M, Kahn GD, Knoll MD; Alliance for Surveillance of Invasive Pneumococci (ASIP) Study Group.Lancet Infect Dis. 2017 Mar;17(3):305-312. doi: 10.1016/S1473-3099(16)30466-2. Epub 2016 Dec 10.PMID: 27956163 Similar articlesSelect item 9733370111.
Drug-resistant Streptococcus pneumoniae in day-care centres in Stockholm County.
Christenson B, Sylvan SP, Noreen B.J Infect. 1998 Jul;37(1):9-14.PMID: 9733370 Similar articles Select item 7673750112.
Capsular serotypes and antibiotic sensitivity of Streptococcus pneumoniae isolated from primary-school children.
Ridgway EJ, Tremlett CH, Allen KD.J Infect. 1995 May;30(3):245-51.PMID: 7673750 Similar articles Select item 3397578113.
Distribution of serotypes and antibiotic resistance among pneumococci in Northern Ireland.
Lafong AC, Crothers E, Bamford KB, Rooney PJ.J Infect. 1988 May;16(3):235-42.PMID: 3397578 Similar articlesSelect item 28668654114.

Hình 3
Measurement of pneumococcal IgG antibody, carriage and infection with Streptococcus pneumoniae in children under five years of age with acute respiratory infection in Niger.
Ibrahim DD, Ousmane S, Moumouni K, Mahamane AE.J Infect Public Health. 2017 Sep - Oct;10(5):657-660. doi: 10.1016/j.jiph.2017.05.007. Epub 2017 Jun 28.PMID: 28668654 Free Article Similar articles Select item 15620019115.
[Evolution of Streptococcus pneumoniae antibiotic resistance in Abidjan: update on nasopharyngeal carriage, from 1997 to 2001].
Kacou-N'douba A, Guessennd-Kouadio N, Kouassi-M'bengue A, Dosso M.Med Mal Infect. 2004 Feb;34(2):83-5. French. PMID: 15620019 Similar articles Select item 10577795116.
The bacteriology of the nasopharynx in childhood.
Leiberman A, Dagan R, Leibovitz E, Yagupsky P, Fliss DM.Int J Pediatr Otorhinolaryngol. 1999 Oct 5;49 Suppl 1:S151-3.PMID: 10577795 Similar articles Select item 9142458117.
Increase in high resistance to penicillin of clinical isolates of Streptococcus pneumoniae in Cádiz, Spain.
García-Martos P, Galán F, Marín P, Mira J.Chemotherapy. 1997 May-Jun;43(3):179-81.PMID: 9142458 Similar articles Select item 29588913118.
Dynamics of Colonization of Streptococcus pneumoniae Strains in Healthy Peruvian Children.
Nelson KN, Grijalva CG, Chochua S, Hawkins PA, Gil AI, Lanata CF, Griffin MR, Edwards KM, Klugman KP, Vidal JE.Open Forum Infect Dis. 2018 Feb 17;5(3):ofy039. doi: 10.1093/ofid/ofy039. eCollection 2018 Mar.PMID: 29588913 Free PMC Article Similar articles Select item 29699525119.
Risk factors for carriage of Streptococcus pneumoniae in children.
Koliou MG, Andreou K, Lamnisos D, Lavranos G, Iakovides P, Economou C, Soteriades ES.BMC Pediatr. 2018 Apr 26;18(1):144. doi: 10.1186/s12887-018-1119-6.PMID: 29699525 Free PMC Article Similar articles Select item 28430673120.
Antimicrobial Resistant Streptococcus pneumoniae: Prevalence, Mechanisms, and Clinical Implications.
Cherazard R, Epstein M, Doan TL, Salim T, Bharti S, Smith MA.Am J Ther. 2017 May;24(3):e361-e369. doi: 10.1097/MJT.0000000000000551. Review.PMID: 28430673 Similar articles
Effect of penicillin prophylaxis on nasopharyngeal colonization with Streptococcus pneumoniae in children with sickle cell anemia.
Anglin DL, Siegel JD, Pacini DL, Smith SJ, Adams G, Buchanan GR.J Pediatr. 1984 Jan;104(1):18-22.PMID: 6690671 Similar articlesSelect item 26859410122.
Dynamics of nasopharyngeal pneumococcal carriage during the course of viral bronchiolitis.
Faber TE, Schuurs TA, Veeger NJ, Hennus MP, Bont LJ.Pediatr Pulmonol. 2016 Aug;51(8):863-7. doi: 10.1002/ppul.23390. Epub 2016 Feb 9.PMID: 26859410 Similar articlesSelect item 26261387123.
Representation of Streptococcus Pneumoniae in Outpatient Population of Sarajevo Canton.
Aljicevic M, Karcic E, Bektas S, Karcic B.Med Arch. 2015 Jun;69(3):177-80. doi: 10.5455/medarh.2015.69.177-180. Epub 2015 Jun 10.PMID: 26261387 Free PMC Article Similar articles Select item 15679234124.
[Epidemiology and antimicrobial resistance of Streptococcus pneumoniae strains isolated in Ile de France area during 2001].
Demachy MC, Faibis F, Artigou A, Benoit C, Cambau E, Cecille A, Chachaty E, Chaplain C, Cormier P, Cousinard F, Decotte JC, Demontrond D, Dublanchet A, Dupeyron C, Farges A, Ferre B, Fremaux AP, Galanti MJ, Gallet C, Guiet P, Hacquard B, Hornstein M, Legrand P, Le Manach F, Lucet N, Malbrunot C, Mangeol A, Mathieu D, Otterbein G, Pateyron F, Poilane I, Pollet J, Rabenja T, Spicq C.Med Mal Infect. 2004 Jul;34(7):303-9. French. PMID: 15679234 Similar articlesSelect item 27161634125.
In Vitro Activity of Lefamulin Tested against Streptococcus pneumoniae with Defined Serotypes, Including Multidrug-Resistant Isolates Causing Lower Respiratory Tract Infections in the United States.
Mendes RE, Farrell DJ, Flamm RK, Talbot GH, Ivezic-Schoenfeld Z, Paukner S, Sader HS.Antimicrob Agents Chemother. 2016 Jun 20;60(7):4407-11. doi: 10.1128/AAC.00627-16. Print 2016 Jul.PMID: 27161634 Free PMC Article Similar articlesSelect item 29157954126.
Activity of omadacycline tested against Streptococcus pneumoniae from a global surveillance program (2014).
Pfaller MA, Rhomberg PR, Huband MD, Flamm RK.Diagn Microbiol Infect Dis. 2018 Feb;90(2):143-147. doi: 10.1016/j.diagmicrobio.2017.10.010. Epub 2017 Oct 19.PMID: 29157954 Similar articlesSelect item 9538599127.
Susceptibility pattern of Streptococcus pneumoniae among pre-school children in Kota Bharu, Malaysia.
Malik AS, Ismail A, Pennie RA, Naidu JV.J Trop Pediatr. 1998 Feb;44(1):10-4. doi: 10.1093/tropej/44.1.10.PMID: 9538599 Similar articlesSelect item 28922566128.
Streptococcus pneumoniae and chronic endobronchial infections in childhood.
Hare KM, Leach AJ, Smith-Vaughan HC, Chang AB, Grimwood K.Pediatr Pulmonol. 2017 Dec;52(12):1532-1545. doi: 10.1002/ppul.23828. Epub 2017 Sep 18. Review.PMID: 28922566 Similar articlesSelect item 23564331129.
Nationwide survey of the development of drug-resistant pathogens in the pediatric field in 2007 and 2010: drug sensitivity of Streptococcus pneumoniae in Japan (second report).
Tajima T, Sato Y, Toyonaga Y, Hanaki H, Sunakawa K.J Infect Chemother. 2013 Jun;19(3):510-6. doi: 10.1007/s10156-013-0593-x. Epub 2013 Apr 7.PMID: 23564331 Free PMC Article Similar articles Select item 8648528130.
Resisting the urge to prescribe.
Edwards KM.J Pediatr. 1996 Jun;128(6):729-30. No abstract available. PMID: 8648528 Similar articles Select item 28575365131.
Density of Upper Respiratory Colonization With Streptococcus pneumoniae and Its Role in the Diagnosis of Pneumococcal Pneumonia Among Children Aged <5 Years in the PERCH Study.
Baggett HC, Watson NL, Deloria Knoll M, Brooks WA, Feikin DR, Hammitt LL, Howie SRC, Kotloff KL, Levine OS, Madhi SA, Murdoch DR, Scott JAG, Thea DM, Antonio M, Awori JO, Baillie VL, DeLuca AN, Driscoll AJ, Duncan J, Ebruke BE, Goswami D, Higdon MM, Karron RA, Moore DP, Morpeth SC, Mulindwa JM, Park DE, Paveenkittiporn W, Piralam B, Prosperi C, Sow SO, Tapia MD, Zaman K, Zeger SL, O'Brien KL; PERCH Study Group .Clin Infect Dis. 2017 Jun 15;64(suppl_3):S317-S327. doi: 10.1093/cid/cix100.PMID: 28575365 Free PMC Article Similar articles Select item 27316956132.
The blp Locus of Streptococcus pneumoniae Plays a Limited Role in the Selection of Strains That Can Cocolonize the Human Nasopharynx.
Valente C, Dawid S, Pinto FR, Hinds J, Simões AS, Gould KA, Mendes LA, de Lencastre H, Sá-Leão R.Appl Environ Microbiol. 2016 Aug 15;82(17):5206-15. doi: 10.1128/AEM.01048-16. Print 2016 Sep 1.PMID: 27316956 Free PMC Article Similar articles Select item 30078238133.
[Clinical characteristics and antimicrobial resistance of pneumococcal infections from 9 children's hospitals in 2016].
Fang C, Chen XJ, Zhou MM, Chen YH, Zhao RZ, Deng JK, Jing CM, Xu HM, Yang JH, Chen YP, Zhang H, Zhang T, Cao SC, Deng HL, Wang CQ, Wang AM, Yu H, Wang SF, Lin AW, Wang X, Cao Q.Zhonghua Er Ke Za Zhi. 2018 Aug 2;56(8):582-586. doi: 10.3760/cma.j.issn.0578-1310.2018.08.005. Chinese. PMID: 30078238Similar articles Select item 28545041134.
Effect of early measles vaccine on pneumococcal colonization: A randomized trial from Guinea-Bissau.
Hansen NS, Byberg S, Hervig Jacobsen L, Bjerregaard-Andersen M, Jensen AKG, Martins C, Aaby P, Skov Jensen J, Stabell Benn C, Whittle H.PLoS one. 2017 May 17;12(5):e0177547. doi: 10.1371/journal.pone.0177547. eCollection 2017.PMID: 28545041 Free PMC Article Similar articles Select item 30253754135.
Resistant Streptococcus pneumoniae strains in children with acute otitis media- high risk of persistent colonization after treatment.
Korona-Glowniak I, Zychowski P, Siwiec R, Mazur E, Niedzielska G, Malm A.BMC Infect Dis. 2018 Sep 25;18(1):478. doi: 10.1186/s12879-018-3398-9.PMID: 30253754 Free PMC Article Similar articles Select item 12630717136.
Percentage, bacterial etiology and antibiotic susceptibility of acute respiratory infection and pneumonia among children in rural Senegal.
Echave P, Bille J, Audet C, Talla I, Vaudaux B, Gehri M.J Trop Pediatr. 2003 Feb;49(1):28-32. doi: 10.1093/tropej/49.1.28.PMID: 12630717 Similar articlesSelect item 8522781137.
Problems in the management of penicillin-resistant pneumococci.
Boswell TC, Smith EG, Ayres JG.J Hosp Infect. 1995 Jul;30(3):233-5. No abstract available. PMID: 8522781 Similar articles Select item 27001799138.
Multistate Outbreak of Respiratory Infections Among Unaccompanied Children, June 2014-July 2014.
Tomczyk S, Arriola CS, Beall B, Benitez A, Benoit SR, Berman L, Bresee J, da Gloria Carvalho M, Cohn A, Cross K, Diaz MH, Francois Watkins LK, Gierke R, Hagan JE, Harris AM, Jain S, Kim L, Kobayashi M, Lindstrom S, McGee L, McMorrow M, Metcalf BL, Moore MR, Moura I, Nix WA, Nyangoma E, Oberste MS, Olsen SJ, Pimenta F, Socias C, Thurman K, Waller J, Waterman SH, Westercamp M, Wharton M, Whitney CG, Winchell JM, Wolff B, Kim C.Clin Infect Dis. 2016 Jul 1;63(1):48-56. doi: 10.1093/cid/ciw147. Epub 2016 Mar 21.PMID: 27001799 Similar articlesSelect item 28742023139.
Genome-wide identification of lineage and locus specific variation associated with pneumococcal carriage duration.
Lees JA, Croucher NJ, Goldblatt D, Nosten F, Parkhill J, Turner C, Turner P, Bentley SD.Elife. 2017 Jul 25;6. pii: e26255. doi: 10.7554/eLife.26255.PMID: 28742023 Free PMC Article Similar articlesSelect item 24080503140.
Genomic identification of a novel co-trimoxazole resistance genotype and its prevalence amongst Streptococcus pneumoniae in Malawi.
Cornick JE, Harris SR, Parry CM, Moore MJ, Jassi C, Kamng'ona A, Kulohoma B, Heyderman RS, Bentley SD, Everett DB.J Antimicrob Chemother. 2014 Feb;69(2):368-74. doi: 10.1093/jac/dkt384. Epub 2013 Sep 29. PMID: 24080503 Free PMC Article Similar articles 
Ten years of surveillance for invasive Streptococcus pneumoniae during the era of antiretroviral scale-up and cotrimoxazole prophylaxis in Malawi.
Everett DB, Mukaka M, Denis B, Gordon SB, Carrol ED, van Oosterhout JJ, Molyneux EM, Molyneux M, French N, Heyderman RS.PLoS one. 2011 Mar 15;6(3):e17765. doi: 10.1371/journal.pone.0017765.PMID: 21423577 Free PMC Article Similar articles Select item 10439990142.
Hospital-related outbreak of infection with multidrug-resistant Streptococcus pneumoniae in the Netherlands.
de Galan BE, van Tilburg PM, Sluijter M, Mol SJ, de Groot R, Hermans PW, Jansz AR.J Hosp Infect. 1999 Jul;42(3):185-92.PMID: 10439990 Similar articlesSelect item 16620000143.
Impact of antibiotic administrative restrictions on trends in antibiotic resistance.
Marshall DA, McGeer A, Gough J, Grootendorst P, Buitendyk M, Simonyi S, Green K, Jaszewski B, MacLeod SM, Low DE.Can J Public Health. 2006 Mar-Apr;97(2):126-31.PMID: 16620000 Similar articlesSelect item 29764945144.
A Mechanism of Unidirectional Transformation, Leading to Antibiotic Resistance, Occurs within Nasopharyngeal Pneumococcal Biofilm Consortia.
Lattar SM, Wu X, Brophy J, Sakai F, Klugman KP, Vidal JE.MBio. 2018 May 15;9(3). pii: e00561-18. doi: 10.1128/mBio.00561-18.PMID: 29764945 Free PMC Article Similar articles Select item 29634626145.
Epidemiology of Otitis Media With Otorrhea Among Bangladeshi Children: Baseline Study for Future Assessment of Pneumococcal Conjugate Vaccine Impact.
Naziat H, Saha S, Islam M, Saha S, Uddin MJ, Hussain M, Luby SP, Darmstadt GL, Whitney CG, Gessner BD, Saha SK.Pediatr Infect Dis J. 2018 Jul;37(7):715-721. doi: 10.1097/INF.0000000000002077.PMID: 29634626 Similar articles Select item 28722638146.
Antibiotic Resistance in Young Children in Kilosa District, Tanzania 4 Years after Mass Distribution of Azithromycin for Trachoma Control.
Bloch EM, West SK, Mabula K, Weaver J, Mrango Z, Munoz B, Lietman T, Coles C.Am J Trop Med Hyg. 2017 Sep;97(3):815-818. doi: 10.4269/ajtmh.17-0022. Epub 2017 Jul 19. PMID: 28722638 Free PMC Article Similar articles Select item 24682147.
Streptococcus pneumoniae resistant to erythromycin and clindamycin.
Champion LA, Wald ER, Luddy RE, Schwartz AD.J Pediatr. 1978 Mar;92(3):505-6. No abstract avai lable. PMID: 24682 Similar articlesSelect item 27493063148.
Inflammation-associated cytokine analysis identifies presence of respiratory bacterial pathogens in the nasopharynx.
Pichichero ME, Almudevar A.Pathog Dis. 2016 Aug;74(6). pii: ftw064. doi: 10.1093/femspd/ftw064. Epub 2016 Aug 4.PMID: 27493063 Free PMC Article Similar articles Select item 28566489149.
An evolutionary model to predict the frequency of antibiotic resistance under seasonal antibiotic use, and an application to Streptococcus pneumoniae.
Blanquart F, Lehtinen S, Fraser C.Proc Biol Sci. 2017 May 31;284(1855). pii: 20170679. doi: 10.1098/rspb.2017.0679.PMID: 28566489 Free PMC Article Similar articles Select item 11160543150.
Vitamin A supplementation at birth delays pneumococcal colonization in South Indian infants.
Coles CL, Rahmathullah L, Kanungo R, Thulasiraj RD, Katz J, Santhosham M, Tielsch JM.J Nutr. 2001 Feb;131(2):255-61.PMID: 11160543 Similar articlesSelect item 27187498151.
Current problems associated with the microbiological point-of-care testing of respiratory tract infections in primary care.
Kaman WE, Elshout G, Bindels PJ, Mitsakakis K, Hays JP.Future Microbiol. 2016 May;11:607-10. doi: 10.2217/fmb-2015-0020. No abstract available. PMID: 27187498 Free Article Similar articles Select item 30107993152.
Immunogenicity and protective efficacy of monovalent PCVs containing 22F and 33F polysaccharides in mouse models of colonization and co-infection.
Khan MN, Pryharski K, Pichichero ME.Vaccine. 2018 Sep 11;36(38):5701-5708. doi: 10.1016/j.vaccine.2018.08.017. Epub 2018 Aug 11.PMID: 30107993 Similar articlesSelect item 28489454153.
Acquisition and Transmission of Streptococcus pneumoniae Are Facilitated during Rhinovirus Infection in Families with Children.
Karppinen S, Teräsjärvi J, Auranen K, Schuez-Havupalo L, Siira L, He Q, Waris M, Peltola V.Am J Respir Crit Care Med. 2017 Nov 1;196(9):1172-1180. doi: 10.1164/rccm.201702-0357OC.PMID: 28489454 Similar articlesSelect item 19166124154.
Pneumococcal osteomyelitis: report of one case.
Huang WL, Wuz TM, Yu CK, Cheng YL, Lien C.Pediatr Neonatol. 2008 Dec;49(6):248-53.PMID: 19166124 Free Article Similar articles Select item 28399056155.
The Nasopharyngeal Microbiota of Children With Respiratory Infections in Botswana.
Kelly MS, Surette MG, Smieja M, Pernica JM, Rossi L, Luinstra K, Steenhoff AP, Feemster KA, Goldfarb DM, Arscott-Mills T, Boiditswe S, Rulaganyang I, Muthoga C, Gaofiwe L, Mazhani T, Rawls JF, Cunningham CK, Shah SS, Seed PC.Pediatr Infect Dis J. 2017 Sep;36(9):e211-e218. doi: 10.1097/INF.0000000000001607.PMID: 28399056 Free PMC Article Similar articles Select item 6966684156.
Effect of upper respiratory tract infection on eustachian tube ventilatory function in the preschool child.
Sanyal MA, Henderson FW, Stempel EC, Collier AM, Denny FW.J Pediatr. 1980 Jul;97(1):11-5.PMID: 6966684 Similar articlesSelect item 28195384157.
Air pollution alters Staphylococcus aureus and Streptococcus pneumoniae biofilms, antibiotic tolerance and colonisation.
Hussey SJK, Purves J, Allcock N, Fernandes VE, Monks PS, Ketley JM, Andrew PW, Morrissey JA.Environ Microbiol. 2017 May;19(5):1868-1880. doi: 10.1111/1462-2920.13686. Epub 2017 Feb 28.PMID: 28195384 Similar articlesSelect item 28540858158.
Streptococcus pneumoniae urinary tract infection in pedeatrics.
Pougnet R, Sapin J, De Parscau L, Pougnet L.Ann Biol Clin (Paris). 2017 Jun 1;75(3):348-350. doi: 10.1684/abc.2017.1241.PMID: 28540858 Similar articles Select item 11810605159.
The continuing challenge of lower respiratory tract infections.
Moellering RC Jr.Clin Infect Dis. 2002 Mar 1;34 Suppl 1:S1-3.PMID: 11810605 Similar articles Select item 11582922160.
[Mortality due to Streptococcus pneumoniae infection in children. A 5-year retrospective study in Ile-de-France].
Ovetchkine P, Cohen R, Gaudelus J.Arch Pediatr. 2001 Sep;8 Suppl 4:747s-751s. French. PMID: 11582922 Similar articles 
Rotavirus in nasopharyngeal secretions of children with upper respiratory tract infections.
Fragoso M, Kumar A, Murray DL.Diagn Microbiol Infect Dis. 1986 Jan;4(1):87-8.PMID: 3002710 Similar articles Select item 30153231162.
Pneumococcal Colonization and the Nasopharyngeal Microbiota of Children in Botswana.
Kelly MS, Surette MG, Smieja M, Rossi L, Luinstra K, Steenhoff AP, Goldfarb DM, Pernica JM, Arscott-Mills T, Boiditswe S, Mazhani T, Rawls JF, Cunningham CK, Shah SS, Feemster KA, Seed PC.Pediatr Infect Dis J. 2018 Nov;37(11):1176-1183. doi: 10.1097/INF.0000000000002174.PMID: 30153231 Similar articlesSelect item 24509479163.
Dense genomic sampling identifies highways of pneumococcal recombination.
Chewapreecha C, Harris SR, Croucher NJ, Turner C, Marttinen P, Cheng L, Pessia A, Aanensen DM, Mather AE, Page AJ, Salter SJ, Harris D, Nosten F, Goldblatt D, Corander J, Parkhill J, Turner P, Bentley SD.
Nat Genet. 2014 Mar;46(3):305-309. doi: 10.1038/ng.2895. Epub 2014 Feb 9.PMID: 24509479 Free PMC Article Similar articles Select item 28413102164.
[Antibiotic susceptibility of Staphylococcus aureus and Streptococcus pneumoniae in healthy carrier individuals in primary care in Barcelona area].
Llor C, Boada A, Pons-Vigués M, Grenzner E, Juvé R, Almeda J.Aten Primaria. 2018 Jan;50(1):44-52. doi: 10.1016/j.aprim.2016.12.008. Epub 2017 Apr 14. Spanish. PMID: 28413102 Free Article Similar articles Select item 30131804165.
Toll-Interleukin 1 Receptor Domain-Containing Adaptor Protein 180L Single-Nucleotide Polymorphism Is Associated With Susceptibility to Recurrent Pneumococcal Lower Respiratory Tract Infections in Children.
Siebert JN, Hamann L, Verolet CM, Gameiro C, Grillet S, Siegrist CA, Posfay-Barbe KM.Front Immunol. 2018 Aug 7;9:1780. doi: 10.3389/fimmu.2018.01780. eCollection 2018.PMID: 30131804 Free PMC Article Similar articles Select item 28453405166.
A meta-analysis of antimicrobial susceptibility profiles for pneumococcal pneumonia in sub-Saharan Africa.
Iroh Tam PY, Sadoh AE, Obaro SK.Paediatr Int Child Health. 2018 Feb;38(1):7-15. doi: 10.1080/20469047.2017.1298700. Epub 2017 Apr 28.PMID: 28453405 Similar articlesSelect item 30038420167.
Impact of viral upper respiratory tract infection on the concentration of nasopharyngeal pneumococcal carriage among Kenyan children.
Morpeth SC, Munywoki P, Hammitt LL, Bett A, Bottomley C, onyango CO, Murdoch DR, Nokes DJ, Scott JAG.Sci Rep. 2018 Jul 23;8(1):11030. doi: 10.1038/s41598-018-29119-w.PMID: 30038420 Free PMC Article Similar articles Select item 17699645168.
Validation of nasopharyngeal sampling and culture techniques for detection of Streptococcus pneumoniae in children in Kenya.
Abdullahi O, Wanjiru E, Musyimi R, Glass N, Scott JA.J Clin Microbiol. 2007 Oct;45(10):3408-10. Epub 2007 Aug 15.PMID: 17699645 Free PMC Article Similar articles Select item 29581113169.
Chemotherapy with Phage Lysins Reduces Pneumococcal Colonization of the Respiratory Tract.
Corsini B, Díez-Martínez R, Aguinagalde L, González-Camacho F, García-Fernández E, Letrado P, García P, Yuste J.Antimicrob Agents Chemother. 2018 May 25;62(6). pii: e02212-17. doi: 10.1128/AAC.02212-17. Print 2018 Jun.PMID: 29581113 Similar articlesSelect item 28665684170.
Maturation of the Infant Respiratory Microbiota, Environmental Drivers, and Health Consequences. A Prospective Cohort Study.
Bosch AATM, de Steenhuijsen Piters WAA, van Houten MA, Chu MLJN, Biesbroek G, Kool J, Pernet P, de Groot PCM, Eijkemans MJC, Keijser BJF, Sanders EAM, Bogaert D.Am J Respir Crit Care Med. 2017 Dec 15;196(12):1582-1590. doi: 10.1164/rccm.201703-0554OC.PMID: 28665684 Similar articles Select item 26067932171.
Climate induces seasonality in pneumococcal transmission.
Numminen E, Chewapreecha C, Turner C, Goldblatt D, Nosten F, Bentley SD, Turner P, Corander J.Sci Rep. 2015 Jun 12;5:11344. doi: 10.1038/srep11344. Erratum in: Sci Rep. 2016;6:23307. PMID: 26067932 Free PMC Article Similar articles Select item 29603797172.
Reductions in otitis and other respiratory tract infections following childhood pneumococcal vaccination.
Johansson Kostenniemi U, Palm J, Silfverdal SA.Acta Paediatr. 2018 Mar 30. doi: 10.1111/apa.14345. [Epub ahead of print]. PMID: 29603797 Similar articlesSelect item 6839864173.
The pneumococcus and the mouse protection test: importance of the lag phase in vivo.
Frimodt-Møller N, Sebbesen O, Frølund Thomsen V.Chemotherapy. 1983;29(2):128-34.PMID: 6839864 Similar articles Select item 30061194174.
Clinical relevance of bacterial resistance in lower respiratory tract infection in primary care: secondary analysis of a multicentre European trial.
Teepe J, Broekhuizen BD, Goossens H, Hordijk PM, Loens K, Lammens C, Ieven M, Little P, Butler CC, Coenen S, Godycki-Cwirko M, Henriques-Normark B, Verheij TJ; GRACE consortium.Br J Gen Pract. 2018 Sep;68(674):e627-e632. doi: 10.3399/bjgp18X698333. Epub 2018 Jul 30.PMID: 30061194 Similar articlesSelect item 28835542175.
Host population structure and treatment frequency maintain balancing selection on drug resistance.
Cobey S, Baskerville EB, Colijn C, Hanage W, Fraser C, Lipsitch M.J R Soc Interface. 2017 Aug;14(133). pii: 20170295. doi: 10.1098/rsif.2017.0295.PMID: 28835542 Free PMC Article Similar articles Select item 26744193176.
Antibiotic Use, Its Resistance in Nepal and Recommendations for Action: A Situation Analysis.
Basnyat B, Pokharel P, Dixit S, Giri S.J Nepal Health Res Counc. 2015 May-Aug;13(30):102-11.PMID: 26744193 Similar articles Select item 26472172177.
Immune ageing and susceptibility to Streptococcus pneumoniae.
Gonçalves MT, Mitchell TJ, Lord JM.Biogerontology. 2016 Jun;17(3):449-65. doi: 10.1007/s10522-015-9614-8. Epub 2015 Oct 15. Review.PMID: 26472172 Similar articlesSelect item 29866907178.
Enzymatic Hydrolysis of Pneumococcal Capsular Polysaccharide Renders the Bacterium Vulnerable to Host Defense.
Middleton DR, Paschall AV, Duke JA, Avci FY.Infect Immun. 2018 Jun 4. pii: IAI.00316-18. doi: 10.1128/IAI.00316-18. [Epub ahead of print]. PMID: 29866907 Similar articlesSelect item 29119707179.
Impaired expression of CXCL5 and matrix metalloproteinases in the lungs of mice with high susceptibility to Streptococcus pneumoniae infection.
Mancuso RI, Miyaji EN, Silva CCF, Portaro FV, Soares-Schanoski A, Ribeiro OG, Oliveira MLS.Immun Inflamm Dis. 2018 Mar;6(1):128-142. doi: 10.1002/iid3.205. Epub 2017 Nov 9.PMID: 29119707 Free PMC Article Similar articles Select item 29765237180.
Comparative genomic analysis of multidrug-resistant Streptococcus pneumoniae isolates.
Pan F, Zhang H, Dong X, Ye W, He P, Zhang S, Zhu JX, Zhong N.Infect Drug Resist. 2018 May 3;11:659-670. doi: 10.2147/IDR.S147858. eCollection 2018.PMID: 29765237 Free PMC Article Similar articles 
Impact of nasopharyngeal microbiota on the development of respiratory tract diseases.
Esposito S, Principi N.Eur J Clin Microbiol Infect Dis. 2018 Jan;37(1):1-7. doi: 10.1007/s10096-017-3076-7. Epub 2017 Aug 9. Review.PMID: 28795339 Similar articlesSelect item 29359142182.
Evaluation of Two Supplemented Culture Media for Long-Term, Room-Temperature Preservation of Streptococcus pneumoniae Strains.
Quintero Moreno B, Araque M, Mendoza E.Biomed Res Int. 2017;2017:1218798. doi: 10.1155/2017/1218798. Epub 2017 Nov 22.PMID: 29359142 Free PMC Article Similar articles Select item 30127421183.
A choline binding polypeptide of LytA inhibits the growth of Streptococcus pneumoniae by binding to choline in the cell wall.
Zhang Z, Zhang X, Zhang L, Wang G, Zeng J, Zhang J, Hu X, Zhou Y.J Antibiot (Tokyo). 2018 Aug 20. doi: 10.1038/s41429-018-0091-6. [Epub ahead of print]. PMID: 30127421 Similar articlesSelect item 28328284184.
Non-encapsulated Streptococcus pneumoniae, vaccination as a measure to interfere with horizontal gene transfer.
Langereis JD, de Jonge MI.Virulence. 2017 Aug 18;8(6):637-639. doi: 10.1080/21505594.2017.1309492. Epub 2017 Mar 22. No abstract available. PMID: 28328284 Free PMC Article Similar articles Select item 29448981185.
Treatment and prevention of invasive pneumococcal disease.
Domínguez-Alegría AR, Pintado V, Barbolla I.Rev Clin Esp. 2018 Jun - Jul;218(5):244-252. doi: 10.1016/j.rce.2018.01.004. Epub 2018 Feb 12. English, Spanish. PMID: 29448981 Similar articlesSelect item 29061707186.
Cell invasion and pyruvate oxidase derived H2O2 are critical for Streptococcus pneumoniae mediated cardiomyocyte killing.
Brissac T, Shenoy AT, Patterson LA, Orihuela CJ.Infect Immun. 2017 Oct 23. pii: IAI.00569-17. doi: 10.1128/IAI.00569-17. [Epub ahead of print], PMID: 29061707 Free PMC Article Similar articles Select item 7658274187.
Delivery of oxygen to children with lower respiratory tract infection.
Regelmann WE.J Pediatr. 1995 Sep;127(3):427-8. No abstract available. PMID: 7658274 Similar articles Select item 29744087188.
Streptococcus pneumoniae as a cause of lactational mastitis: a case report.
Hald SV, Schønheyder HC.Clin Case Rep. 2018 Mar 25;6(5):917-919. doi: 10.1002/ccr3.1488. eCollection 2018 May.PMID: 29744087 Free PMC Article Similar articles Select item 27956111189.
Antibiotic resistance: A current epilogue.
Dodds DR.Biochem Pharmacol. 2017 Jun 15;134:139-146. doi: 10.1016/j.bcp.2016.12.005. Epub 2016 Dec 10. Review.PMID: 27956111 Similar articlesSelect item 21023191190.
Pneumococcic stomatitis.
OCHS CJ.J Pediatr. 1946 Apr;28:481. No abstract available. PMID: 21023191 Similar articlesSelect item 7776391191.
Caretaker compliance with different antibiotic formulations for treatment of childhood pneumonia.
Ellerbeck E, Khallaf N, el Ansary KS, Moursi S, Black R.J Trop Pediatr. 1995 Apr;41(2):103-8. doi: 10.1093/tropej/41.2.103. PMID: 7776391 Similar articles Select item 29140429192.
Factors Associated With 30-Day Mortality Rate in Respiratory Infections Caused by Streptococcus pneumoniae.
Cheng MP, Bogoch II, Green K, Plevneshi A, Rudnick W, Shigayeva A, McGeer A, Lee TC; Toronto Invasive Bacterial Diseases Network .Clin Infect Dis. 2018 Apr 3;66(8):1282-1285. doi: 10.1093/cid/cix999.PMID: 29140429 Similar articlesSelect item 30217861193.
Mass antibiotic distribution to reduce mortality among preschool children?
Berkley JA.Arch Dis Child. 2018 Sep 14. pii: archdischild-2018-315451. doi: 10.1136/archdischild-2018-315451. [Epub ahead of print] No abstract available. PMID: 30217861 Similar articles Select item 28800258194.
Nasopharyngeal Microbiota: Gatekeepers or Fortune Tellers of Susceptibility to Respiratory Tract Infections?
Huang YJ.Am J Respir Crit Care Med. 2017 Dec 15;196(12):1504-1505. doi: 10.1164/rccm.201707-1470ED. No abstract available. PMID: 28800258 Similar articles 
Drug-resistant Streptococcus pneumoniae.
Campbell GD Jr, Silberman R.Clin Infect Dis. 1998 May;26(5):1188-95. Review.PMID: 9597251 Similar articles Select item 108264512.
Management of community-acquired pneumonia in the era of pneumococcal resistance: a report from the Drug-Resistant Streptococcus pneumoniae Therapeutic Working Group.
Heffelfinger JD, Dowell SF, Jorgensen JH, Klugman KP, Mabry LR, Musher DM, Plouffe JF, Rakowsky A, Schuchat A, Whitney CG.Arch Intern Med. 2000 May 22;160(10):1399-408.PMID: 10826451 Similar articles Select item 151273713.
Antibiotic resistance in Streptococcus pneumoniae: what does the future hold?
Nuermberger EL, Bishai WR.Clin Infect Dis. 2004 May 15;38 Suppl 4:S363-71.PMID: 15127371 Similar articles Select item 115628984.
Drug-resistant Streptococcus pneumoniae infections: clinical importance, drug treatment, and prevention.
Kellner JD.Semin Respir Infect. 2001 Sep;16(3):186-95. Review.PMID: 11562898 Similar articles Select item 188474025.
Antimicrobial-resistant Streptococcus pneumoniae: trends and management.
Jacobs MR.Expert Rev Anti Infect Ther. 2008 Oct;6(5):619-35. doi: 10.1586/14787210.6.5.619. Review.PMID: 18847402 Similar articles Select item 192964206.
Streptococcus pneumoniae: does antimicrobial resistance matter?
Lynch JP 3rd, Zhanel GG.Semin Respir Crit Care Med. 2009 Apr;30(2):210-38. doi: 10.1055/s-0029-1202939. Epub 2009 Mar 18. Review.PMID: 19296420 Similar articles Select item 209342867.
[An update of Streptococcus pneumoniae: from genomic to clinic].
Wintenberger C.Med Mal Infect. 2010 Oct;40(10):605-9. doi: 10.1016/j.medmal.2010.07.014. Epub 2010 Oct 8. Review. French. No abstract available. PMID: 20934286 Similar articles Select item 99519718.
Acute otitis media: management and surveillance in an era of pneumococcal resistance--a report from the Drug-resistant Streptococcus pneumoniae Therapeutic Working Group.
Dowell SF, Butler JC, Giebink GS, Jacobs MR, Jernigan D, Musher DM, Rakowsky A, Schwartz B.Pediatr Infect Dis J. 1999 Jan;18(1):1-9. Review. Erratum in: Pediatr Infect Dis J 1999 Apr;18(4):341. PMID: 9951971 Similar articles Select item 112903109.
Community acquired pneumonia among pediatric outpatients in Salvador, Northeast Brazil, with emphasis on the role of pneumococcus.
Nascimento-Carvalho CM, Lopes AA, Gomes MD, Magalhães MP, Oliveira JR, Vilas-Boas AL, Ferracuti R, Brandileone MC, Guerra ML, Alves NN, Athayde LA, Caldas RM, Barberino MG, Duarte J, Brandão MA, Rocha H, Benguigui Y, Di Fabio JL.Braz J Infect Dis. 2001 Feb;5(1):13-20. Epub 2001 Aug 3.PMID: 11290310Free Article Similar articles Select item 1833902210.
Antimicrobial susceptibilities of Streptococcus pneumoniae isolated from adult patients with community-acquired pneumonia in Japan.
Ishida T, Maniwa K, Kagioka H, Hirabayashi M, onaru K, Tomioka H, Hayashi M, Tomii K, Gohma I, Ito Y, Hirai T, Ito I, Mishima M.Respirology. 2008 Mar;13(2):240-6. doi: 10.1111/j.1440-1843.2007.01214.x.PMID: 18339022 Similar articlesSelect item 1180029611.
Invasive pneumococcal infection and drug-resistant Streptococcus pneumoniae in Thai children.
Pancharoen C, Chongthaleong A, Reinprayoon S, Thisyakorn U.J Med Assoc Thai. 2001 Sep;84(9):1246-50.PMID: 11800296 Similar articles Select item 890316412.
Action plan for drug-resistant Streptococcus pneumoniae. The DRSP Working Group.
Cetron MS, Jernigan DB, Breiman RF.Emerg Infect Dis. 1995 Apr-Jun;1(2):64-5. No abstract available. PMID: 8903164 Free PMC Article Similar articles Select item 1098432513.
Microbiological and pharmacodynamic considerations in the treatment of infection due to antimicrobial-resistant Streptococcus pneumoniae.
Appelbaum PC.Clin Infect Dis. 2000 Aug;31 Suppl 2:S29-34. Review.PMID: 10984325 Similar articlesSelect item 2055804514.
Evolving trends in Streptococcus pneumoniae resistance: implications for therapy of community-acquired bacterial pneumonia.
Jones RN, Jacobs MR, Sader HS.Int J Antimicrob Agents. 2010 Sep;36(3):197-204. doi: 10.1016/j.ijantimicag.2010.04.013. Epub 2010 Jun 16. Review.PMID: 20558045 Similar articlesSelect item 1125732715.
Clinical outcome of invasive infections in children caused by highly penicillin-resistant Streptococcus pneumoniae compared with infections caused by penicillin-susceptible strains.
Gómez-Barreto D, Calderón-Jaimes E, Rodríguez RS, de los Monteros LE.Arch Med Res. 2000 Nov-Dec;31(6):592-8.PMID: 11257327 Similar articles Select item 1189151316.
Update on pneumococcal infections of the respiratory tract.
Tan TQ.Semin Respir Infect. 2002 Mar;17(1):3-9. Review.PMID: 11891513 Similar articles Select item 1638842917.
Escalation of antimicrobial resistance among Streptococcus pneumoniae: implications for therapy.
Lynch JP 3rd, Zhanel GG.Semin Respir Crit Care Med. 2005 Dec;26(6):575-616. Review.PMID: 16388429 Similar articles Select item 1740890418.
Garenoxacin activity against isolates form patients hospitalized with community-acquired pneumonia and multidrug-resistant Streptococcus pneumoniae.
Jones RN, Sader HS, Stilwell MG, Fritsche TR.Diagn Microbiol Infect Dis. 2007 May;58(1):1-7. Epub 2007 Apr 3.PMID: 17408904 Similar articlesSelect item 1528830619.
A review of clinical failures associated with macrolide-resistant Streptococcus pneumoniae.
Rzeszutek M, Wierzbowski A, Hoban DJ, Conly J, Bishai W, Zhanel GG.Int J Antimicrob Agents. 2004 Aug;24(2):95-104. Review.PMID: 15288306 Similar articles Select item 1512217120.
Clinical relevance of antimicrobial resistance in the management of pneumococcal community-acquired pneumonia.
Feldman C.J Lab Clin Med. 2004 May;143(5):269-83. Review.PMID: 15122171 Similar articles 
Ten-year review of invasive pneumococcal diseases in children and adults from Uruguay: clinical spectrum, serotypes, and antimicrobial resistance.
Hortal M, Camou T, Palacio R, Dibarboure H, García A.Int J Infect Dis. 2000;4(2):91-5.PMID: 10737845 Free Article Similar articles Select item 2263245522.
Risk factors for drug-resistant Streptococcus pneumoniae and antibiotic prescribing practices in outpatient community-acquired pneumonia.
Jenkins TC, Sakai J, Knepper BC, Swartwood CJ, Haukoos JS, Long JA, Price CS, Burman WJ.Acad Emerg Med. 2012 Jun;19(6):703-6. doi: 10.1111/j.1553-2712.2012.01365.x. Epub 2012 May 25.PMID: 22632455 Free Article Similar articles Select item 1294402123.
Comparison of Streptococcus pneumoniae and Haemophilus influenzae susceptibilities from community-acquired respiratory tract infections and hospitalized patients with pneumonia: five-year results for the SENTRY Antimicrobial Surveillance Program.
Gordon KA, Biedenbach DJ, Jones RN.Diagn Microbiol Infect Dis. 2003 Aug;46(4):285-9.PMID: 12944021 Similar articles Select item 827793724.
Drug-resistant Streptococcus pneumoniae--Kentucky and Tennessee, 1993.
Centers for Disease Control and Prevention (CDC).MMWR Morb Mortal Wkly Rep. 1994 Jan 21;43(2):23-6, 31.PMID: 8277937 Similar articles Select item 1566448025.
Efficacy of a new pharmacokinetically enhanced formulation of amoxicillin/clavulanate (2000/125 mg) in adults with community-acquired pneumonia caused by Streptococcus pneumoniae, including penicillin-resistant strains.
File TM, Garau J, Jacobs MR, Wynne B, Twynholm M, Berkowitz E.Int J Antimicrob Agents. 2005 Feb;25(2):110-9.PMID: 15664480 Similar articles Select item 1658564426.
Increase in numbers of beta-lactam-resistant invasive Streptococcus pneumoniae in Brazil and the impact of conjugate vaccine coverage.
Brandileone MC, Casagrande ST, Guerra ML, Zanella RC, Andrade AL, Di Fabio JL.J Med Microbiol. 2006 May;55(Pt 5):567-74.PMID: 16585644 Similar articles Select item 1118744327.
Is drug resistance affecting treatment outcomes?
Bishai W.Am J Manag Care. 2000 Dec;6(23 Suppl):S1197-201. Review.PMID: 11187443 Free Article Similar articles Select item 1118744228.
Resistance among Streptococcus pneumoniae: patterns, mechanisms, interpreting the breakpoints.
Brueggemann AB, Doern GV.Am J Manag Care. 2000 Dec;6(23 Suppl):S1189-96. Review.PMID: 11187442 Free Article Similar articles Select item 1666992429.
Clinical experience in the management of community-acquired pneumonia: lessons from the use of fluoroquinolones.
Carratalá J, Martín-Herrero JE, Mykietiuk A, García-Rey C.Clin Microbiol Infect. 2006 May;12 Suppl 3:2-11. Review.PMID: 16669924 Free Article Similar articlesSelect item 1551947030.
Community-acquired pneumonia: new management strategies for evolving pathogens and antimicrobial susceptibilities.
Klugman KP, Low DE, Metlay J, Pechere JC, Weiss K.Int J Antimicrob Agents. 2004 Nov;24(5):411-22. Review.PMID: 15519470 Similar articlesSelect item 1793325631.
[In vitro resistance rates of Streptococcus pneumoniae and Haemophilus influenzae clinical isolates to the antibiotics used in therapy].
Uncu H, Colakoğlu S, Turunç T, Demiroğlu YZ, Arslan H.Mikrobiyol Bul. 2007 Jul;41(3):441-6. Turkish. PMID: 17933256 Similar articles Select item 1933695432.
Efficacy of azithromycin in the treatment of community-acquired pneumonia, including patients with macrolide-resistant Streptococcus pneumoniae infection.
Yanagihara K, Izumikawa K, Higa F, Tateyama M, Tokimatsu I, Hiramatsu K, Fujita J, Kadota J, Kohno S.Intern Med. 2009;48(7):527-35. Epub 2009 Apr 1.PMID: 19336954 Free Article Similar articles Select item 1597949433.
Community-acquired bacteraemic pneumococcal pneumonia in adults: effect of diminished penicillin susceptibility on clinical outcome.
Bonnard P, Lescure FX, Douadi Y, Schmit JL, Jounieaux V, Laurans G, Eb F, Ducroix JP.J Infect. 2005 Jul;51(1):69-76.PMID: 15979494 Similar articlesSelect item 1712499334.
Risk factors and clinical outcomes of penicillin resistant S. pneumoniae community-acquired pneumonia in Khon Kaen, Thailand.
Reechaipichitkul W, Assawasanti K, Chaimanee P.Southeast Asian J Trop Med Public Health. 2006 Mar;37(2):320-6.PMID: 17124993 Similar articlesSelect item 1596450135.
Therapeutic options among broad-spectrum beta-lactams for infections caused by levofloxacin-nonsusceptible Streptococcus pneumoniae.
Jones RN, Fritsche TR, Sader HS.Diagn Microbiol Infect Dis. 2005 Jun;52(2):129-33.PMID: 15964501 Similar articlesSelect item 1254559236.
Penicillin resistance in pneumococcal pneumonia. Antibiotics with low resistance potential are effective and pose less risk.
Cunha BA.Postgrad Med. 2003 Jan;113(1):42-4, 47-8, 52-4. Review.PMID: 12545592 Similar articlesSelect item 1710126037.
Geographically-based evaluation of multidrug resistance trends among Streptococcus pneumoniae in the USA: findings of the FAST surveillance initiative (2003-2004).
Draghi DC, Jones ME, Sahm DF, Tillotson GS.Int J Antimicrob Agents. 2006 Dec;28(6):525-31. Epub 2006 Nov 13.PMID: 17101260 Similar articlesSelect item 860417338.
Minimizing the impact of drug-resistant Streptococcus pneumoniae (DRSP). A strategy from the DRSP Working Group.
Jernigan DB, Cetron MS, Breiman RF.JAMA. 1996 Jan 17;275(3):206-9.PMID: 8604173 Similar articlesSelect item 1599557939.
Pneumolysin as a vaccine and drug target in the prevention and treatment of invasive pneumococcal disease.
Cockeran R, Anderson R, Feldman C.Arch Immunol Ther Exp (Warsz). 2005 May-Jun;53(3):189-98. Review.PMID: 15995579 Similar articlesSelect item 1197912940.
Streptococcus pneumoniae respiratory tract infections.
Klugman KP, Feldman C.Curr Opin Infect Dis. 2001 Apr;14(2):173-9. Review.PMID: 11979129 Similar articles